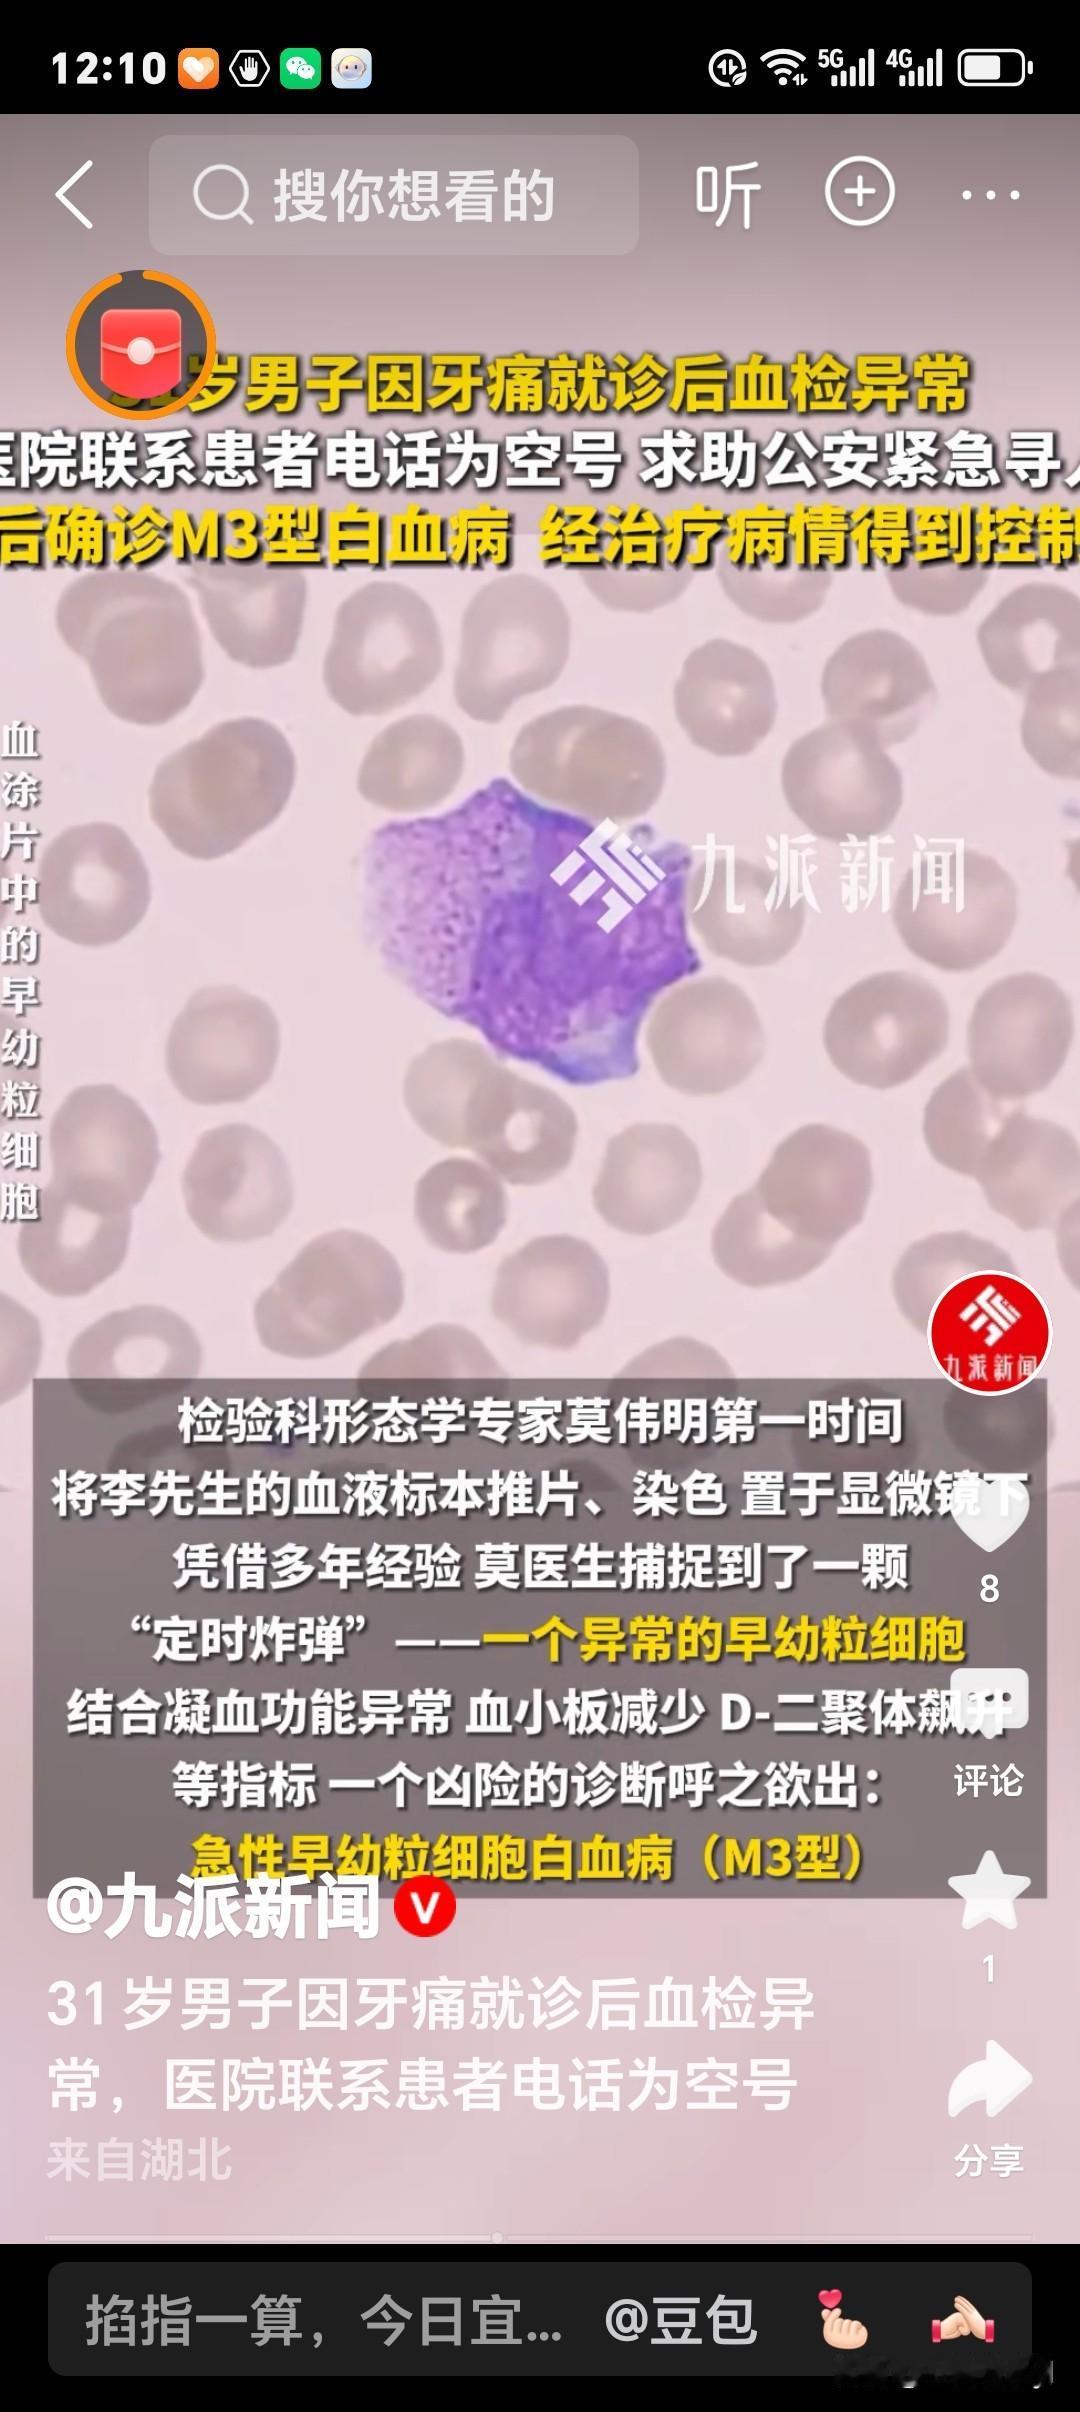

太惊险了!近日杭州31岁男子因牙痛来医院就诊,没想到竟然惊动了公安局。
李先生因为牙痛来医院就诊,接诊医生为他开具了血常规、凝血功能等常规检查,检验结果却让所有人的心悬了起来。
白细胞 、血小板 、纤维蛋白原等多项指标显著异常,检验科夜班同事察觉到危险信号,立刻在科室微信群里郑重交班:
“请形态学专家第一时间复核血涂片”!
检验科形态学医生第一时间将李先生的血液标本推片、染色 置于显微镜下,凭借多年经验 莫医生捕捉到了一颗“定时炸弹”——一个异常的早幼粒细胞。结合凝血功能异常 ,血小板减少 D-二聚体飙升
等指标 ,一个凶险的诊断呼之欲出:急性早幼粒细胞白血病(M3型)
“必须立刻找到患者!” 当医生们试图联系李先生时,发现他在医院预留的电话号码竟是空号。血液科蔡医师当机立断,将情况上报至医务科、 门诊办 、信息科。
最终在医院多部门协调下, 通过公安部门协助,终于成功联系上李先生,李先生返院后, 蔡医师全程陪同,开通绿色通道 ,以最快速度完成入院检查
,检验科同步加急完成骨髓涂片分析 。
结果证实:M3型白血病 ,且患者已出现高凝状态, 病情刻不容缓。血液科团队立即启动靶向治疗——维甲酸诱导分化治疗同步纠正凝血异常。用药后李先生的D-二聚体 血小板水平逐步好转,病情迅速得到控制。
李先生是极其不幸的,年纪轻轻就遭遇凶险的白血病;但他又是极其幸运的,及时得到救治,而且它是目前治愈率最高的白血病类型之一。
如果医生们因为电话是空号,就放任不管,那李先生的后果不堪设想,不止挽救了李先生的性命,也挽救了一个家庭的幸福。
这家医院的医生们真正体现了医者仁心,这种“必须立刻找到患者”的执着,是对生命最大的敬畏。在如今快节奏的社会中,这种“不抛弃、不放弃”的责任心显得尤为珍贵。
为白衣天使们点赞!